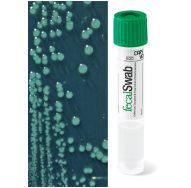

Система Fecal-Swab пробирка 12х80 мм с завинчивающейся крышкой, с 2 мл модифицированной среды Кэри Блейр и универсальным велюр-тампоном на пластиковом аппликаторе
Сваб-система FecalSwab, велюр-тампон, САRY BLAIR, 2 мл, 12х80 мм
Возможно вас заинтересуют

артикул: И3ИП-136 остаток: нет в наличии
Шприц иньекционный Луер, стерил., емк 5 мл, с иглой 22 G (0,7х40 мм) BD
цена формируется

артикул: И3ИП-263 остаток: нет в наличии
Игла иньекц. Луер для птиц № 0,7х10, уп. 12 шт. ЭКО
цена формируется

артикул: И3ИП-436 остаток: нет в наличии
Шприц-дозатор Henke Roux-Revolver, емк 30 мл,
цена формируется

артикул: И3ИП-046 остаток: нет в наличии
Игла иньекционная Рекорд, для блокад № 1,5 х 180 , уп.10шт
цена формируется

артикул: И3ИП-393 остаток: нет в наличии
Шприц-вакцинатор "Ферро-матик" ,(аналог Ветматика) емк 5 мл ,под флакон сверху
цена формируется

артикул: И3ИП-075 остаток: нет в наличии
Цилиндр стеклянный, Сокорекс, 1 мл, без поршня
цена формируется

артикул: И3ИП-061 остаток: нет в наличии
Канюля переходная, с иглы Рекорд на шприц Луер, Кл-34, Ворсма
цена формируется

артикул: И4ХР-197 остаток: нет в наличии
Канюля-Браунюля, интравенозная, с инъекц. портом, серая, 16G
цена формируется

артикул: 3711015 остаток: нет в наличии
Игла инъекционная, Луер-Лок, 1,0х15, 19G, для птиц, Сокорекс, 371.1015, упак. 12 шт.
цена формируется

артикул: И3ИП-599 остаток: нет в наличии
Удлинитель к шприцу-вакцинатору Сокорекс ( трубка жесткая) дл. 30 см. Код. 1.187.30
цена формируется

артикул: И3ИП-001 остаток: нет в наличии
Держатель иглы для взятия крови у животных
цена формируется